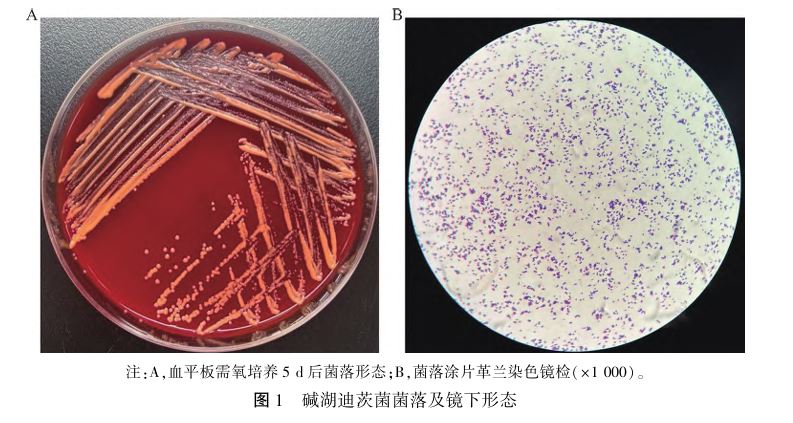
1764643129242427.jpg 1764643129242427.jpg

碱湖迪茨菌致化脓性关节炎1例
作者:顾敏
,许雨乔,倪芳,夏文颖等,南京医科大学第一附属医院检验学部,国家医学检验临床医学研究中心分中心
A迪茨菌属(Dietzia)隶属于放线菌门、放线菌纲、放线菌目、棒杆菌亚目、迪茨菌科,是一类需氧的革兰阳性菌,触酶阳性。 该菌属因其表型相似曾被归为红球菌属,直至1995年被命名为一个新的菌属[1]。 迪茨菌属在自然界中广泛存在,偶从临床标本中分离得到,引起的临床感染罕见[2]。 碱湖迪茨菌(Dietzia natronolimnaios)1998 年首次从东非盐碱苏打湖中分离并命名,目前仅有2例碱湖迪茨菌与人类感染相关的报道,包括眼内炎和心内膜炎[3⁃4]。 2024 年 1 月,我们从 1 例化脓性关节炎
的患者关节液中分离出碱湖迪茨菌,现报道如下。
1 病历资料
患者女,55岁,既往有高血压
病史3年,因外伤后右膝关节疼痛伴活动受限1月余,于2024年1月2日入住南京医科大学第一附属医院骨科。 患者1月前因车祸外伤后于当地医院行半月板切除术,半月前右膝关节核磁共振结果显示:右膝关节髌上囊、关节腔内见长T1、长T2液体信号影,右膝髂胫束内侧、腘肌囊及髌前皮下滑膜囊积液。 当地医院予以多次抽取积液及玻璃酸钠治疗,效果均不佳,有无抗菌治疗不详。 我院行骨科专科检查,视诊示右膝关节稍肿胀,触诊示右侧关节内侧间隙压痛(+)、浮髌试验
(+),动诊示麦氏试验(+)、前抽屉试验
(+)、过屈试验(+)、Lachman 试验(+)。 实验室检查:白细胞 4.64×109/L、C-反应蛋白 79.4mg/ L、血沉91 mm/h。 诊断为右膝化脓性关节炎。1 月5日患者行右侧膝关节清理术,术中留取关节液培养,术后予以头孢呋辛
钠、左氧氟沙星联合抗感染。 关节液培养结果提示碱湖迪茨菌,未调整抗菌治疗方案。 1月15日患者恢复良好,予以出院。
2 微生物检查
2.1 主要仪器与试剂 BactecTM FX 血培养
系统及配套的 Bactec Plus/F 树脂需氧培养瓶和 BactecLytic/ 10 含溶血素厌氧培养瓶(美国Becton Dickin⁃son 公司);Vitek MS 质谱仪及其配套试剂、大肠埃希菌ATCC 8739(法国 BioMérieux 公司);血平板、巧克力平板、E⁃test 试纸条(郑州安图生物公司)。
2.2 细菌培养及鉴定 无菌留取术中关节液后立即接种需氧瓶和厌氧瓶并送至微生物实验室,将培养瓶置于血培养仪中,4d9h后需氧瓶提示阳性报警,培养液涂片
镜下见革兰阳性球菌,将阳性培养液转种至血琼脂平板及巧克力平板,置于5% CO2培养箱35℃培养5d后,血平板见圆形、凸起、光滑的橙红色菌落,见图1A,菌落革兰染色镜下见卵圆形革兰阳性球菌,大小不等,偶呈短棒状,见图1B。用Vitek MS 质谱仪采用基质辅助激光解吸电离飞行时间质谱(MALDI⁃TOF MS)方法对菌株进行鉴定,结果为碱湖迪茨菌(Dietzia natronolimnaios),置信度99.9%)。 使用16S rDNA 基因测序对该菌进行进一步鉴定,由南京擎科公司完成测序,引物序列:F:5′⁃AGAGTTTGATCCTGGCTCAG⁃3′; R:5′⁃GGTTACCTTGTTACGACTT⁃3′,反应条件:98 ℃ 变性10 s,55 ℃退火10 s,72 ℃延伸10 s,循环35次,采·639用ABI 3730 测序仪进行测序,经BLAST比对,测序结果与碱湖迪茨菌(GenBank 登录号:FJ588191.1)99.93%同源。
2.3 药敏试验
采用含5%绵羊血的MHA培养基,用E⁃test 法进行药敏试验,72 h 后观察药敏结果,参照CLSI M24 A2 诺卡菌及其他需氧放线菌选择抗菌药物及折点判读方法[5]。 抗菌药物最小抑菌浓度(MIC)值为:阿米卡星0.75 μg/mL,头孢曲松
0.094 μg/mL,环丙沙星0.016 μg/mL,亚胺培南0.008 μg/ mL,碱湖迪茨菌对以上药物均敏感。 采用金黄色葡萄球菌
ATCC 29213 作为质控菌株,阿米卡星、头孢曲松、环丙沙星、亚胺培南在控。
3 讨论
迪茨菌属隶属于放线菌,属内目前有15个种,其模式菌种为海洋迪茨菌(Dietzia maris),该菌属广泛分布于自然环境中,以土壤和海洋沉积物中最为常见[1]。 迪茨菌属较少从临床标本中分离,属内仅有6个种涉及,包括海洋迪茨菌(Dietzia maris)、乳头状瘤迪茨菌(Dietzia papillomatosis)、橙色迪茨菌(Dietzia aurantiaca)、肉桂色迪茨菌(Dietzia cin⁃namea)、碱湖迪茨菌(Dietzia natronolimnaios)和马赛迪茨菌(Dietzia massiliensis)[2,6⁃7]。 过去迪茨菌属细菌常被认为是环境污染菌或正常菌群,因此其临床意义常被忽略[8]。 1999 年法国学者首次从1名感染性休克
患者的血液中分离出海洋迪茨菌,证实该菌临床致病性[2]。 感染患者多有基础疾病,免疫功能低下,存在侵袭性操作史和外伤史[2⁃4,8⁃10]。 本例报道了首例碱湖迪茨菌引起的化脓性关节炎,患者除存在高血压病史外既往体健,但该患者存在侵袭性诊疗操作及外伤等危险因素,可能是迪茨菌感染的原因之一。迪茨菌属生长缓慢,易漏检,应适当延长培养时间。 该菌不耐酸、不耐醇,镜下可呈球形、短棒状或V型结构,菌落呈圆形、凸起、边缘橙色到珊瑚红色,与红球菌属表型高度相似[2]。 常规表型检测很难正确区分迪茨菌和红球菌,APICoryne板条可错误地将迪茨菌鉴定为红球菌[2]。 MALDI⁃TOF MS作为一种快速、高效的鉴定方法,被实验室广泛使用,研究表明,使用MALDI⁃TOF MS 可准确区分迪茨菌和红球菌,不同品牌质谱仪如 Vitek MS 和Bruker Biotyper 对迪茨菌属均表现出较好的鉴定性能,使用乙醇预处理细菌后鉴定准确率明显提高[11]。 本例使用甲酸-乙腈处理菌落,成功鉴定出碱湖迪茨菌。 16S rRNA基因测序分析可准确鉴定迪茨菌[6]。目前,针对迪茨菌药物敏感性试验的研究较少,且无标准化药敏试验方法及折点判读标准。 本例参考CLSI M24 A2标准选择一线抗菌药物,发现该菌对阿米卡星、头孢曲松、环丙沙星、亚胺培南均敏感。 Sáez⁃Nieto 等[12]采用 E⁃test 法将菌株接种于含5%绵羊血的MHA培养基中,在37℃有氧条件下培养48 h,测定其对8种抗菌药物的敏感性,并参考诺卡氏菌及其他放线菌的折点进行结果判读,结果显示18株迪茨菌对红霉素
耐药率为44.4%,对复方磺胺甲噁唑耐药率为100%,但对阿莫西林/克拉维酸、头孢噻肟
、阿米卡星、环丙沙星、利奈唑胺
、亚胺培南均敏感。 Niwa 等[6]参考 M24⁃A 标准进行菌悬液制备及结果判读,16株临床分离株除对复方磺胺甲噁唑耐药率为56.3%,对其余10种抗菌药物均敏感。 也有文献参考欧洲抗菌药物敏感性试验委员会(EUCAST)折点进行结果判读,该分离株对除红霉素(耐药)和克林霉素(中介)外的所有抗微生物药物均敏感[13]。 现有研究表明,迪茨菌对β-内酰胺类、氨基糖苷类、大环内酯类抗生素和万古霉素
敏感,不同模式菌种间的药物敏感性略有差异,有关迪茨菌的抗菌药敏谱仍需进一步研究[4,6,12]。 迪茨菌感染患者多使用 β-内酰胺类药物进行治疗,多数预后良好,仅1例患者因主动脉夹层
破裂死亡[2⁃4,9⁃10]。综上所述,迪茨菌作为一种潜在的机会性病原体,当临床标本分离出该菌时,应考虑其临床意义及致病性。 免疫功能低下、侵袭性诊疗操作、外伤可能是迪茨菌感染的危险因素。 适当延长培养时间和正确的鉴定手段可提高迪茨菌的检出率。
参考文献略。
来源:临床检验杂志2025年8月第43卷第8期